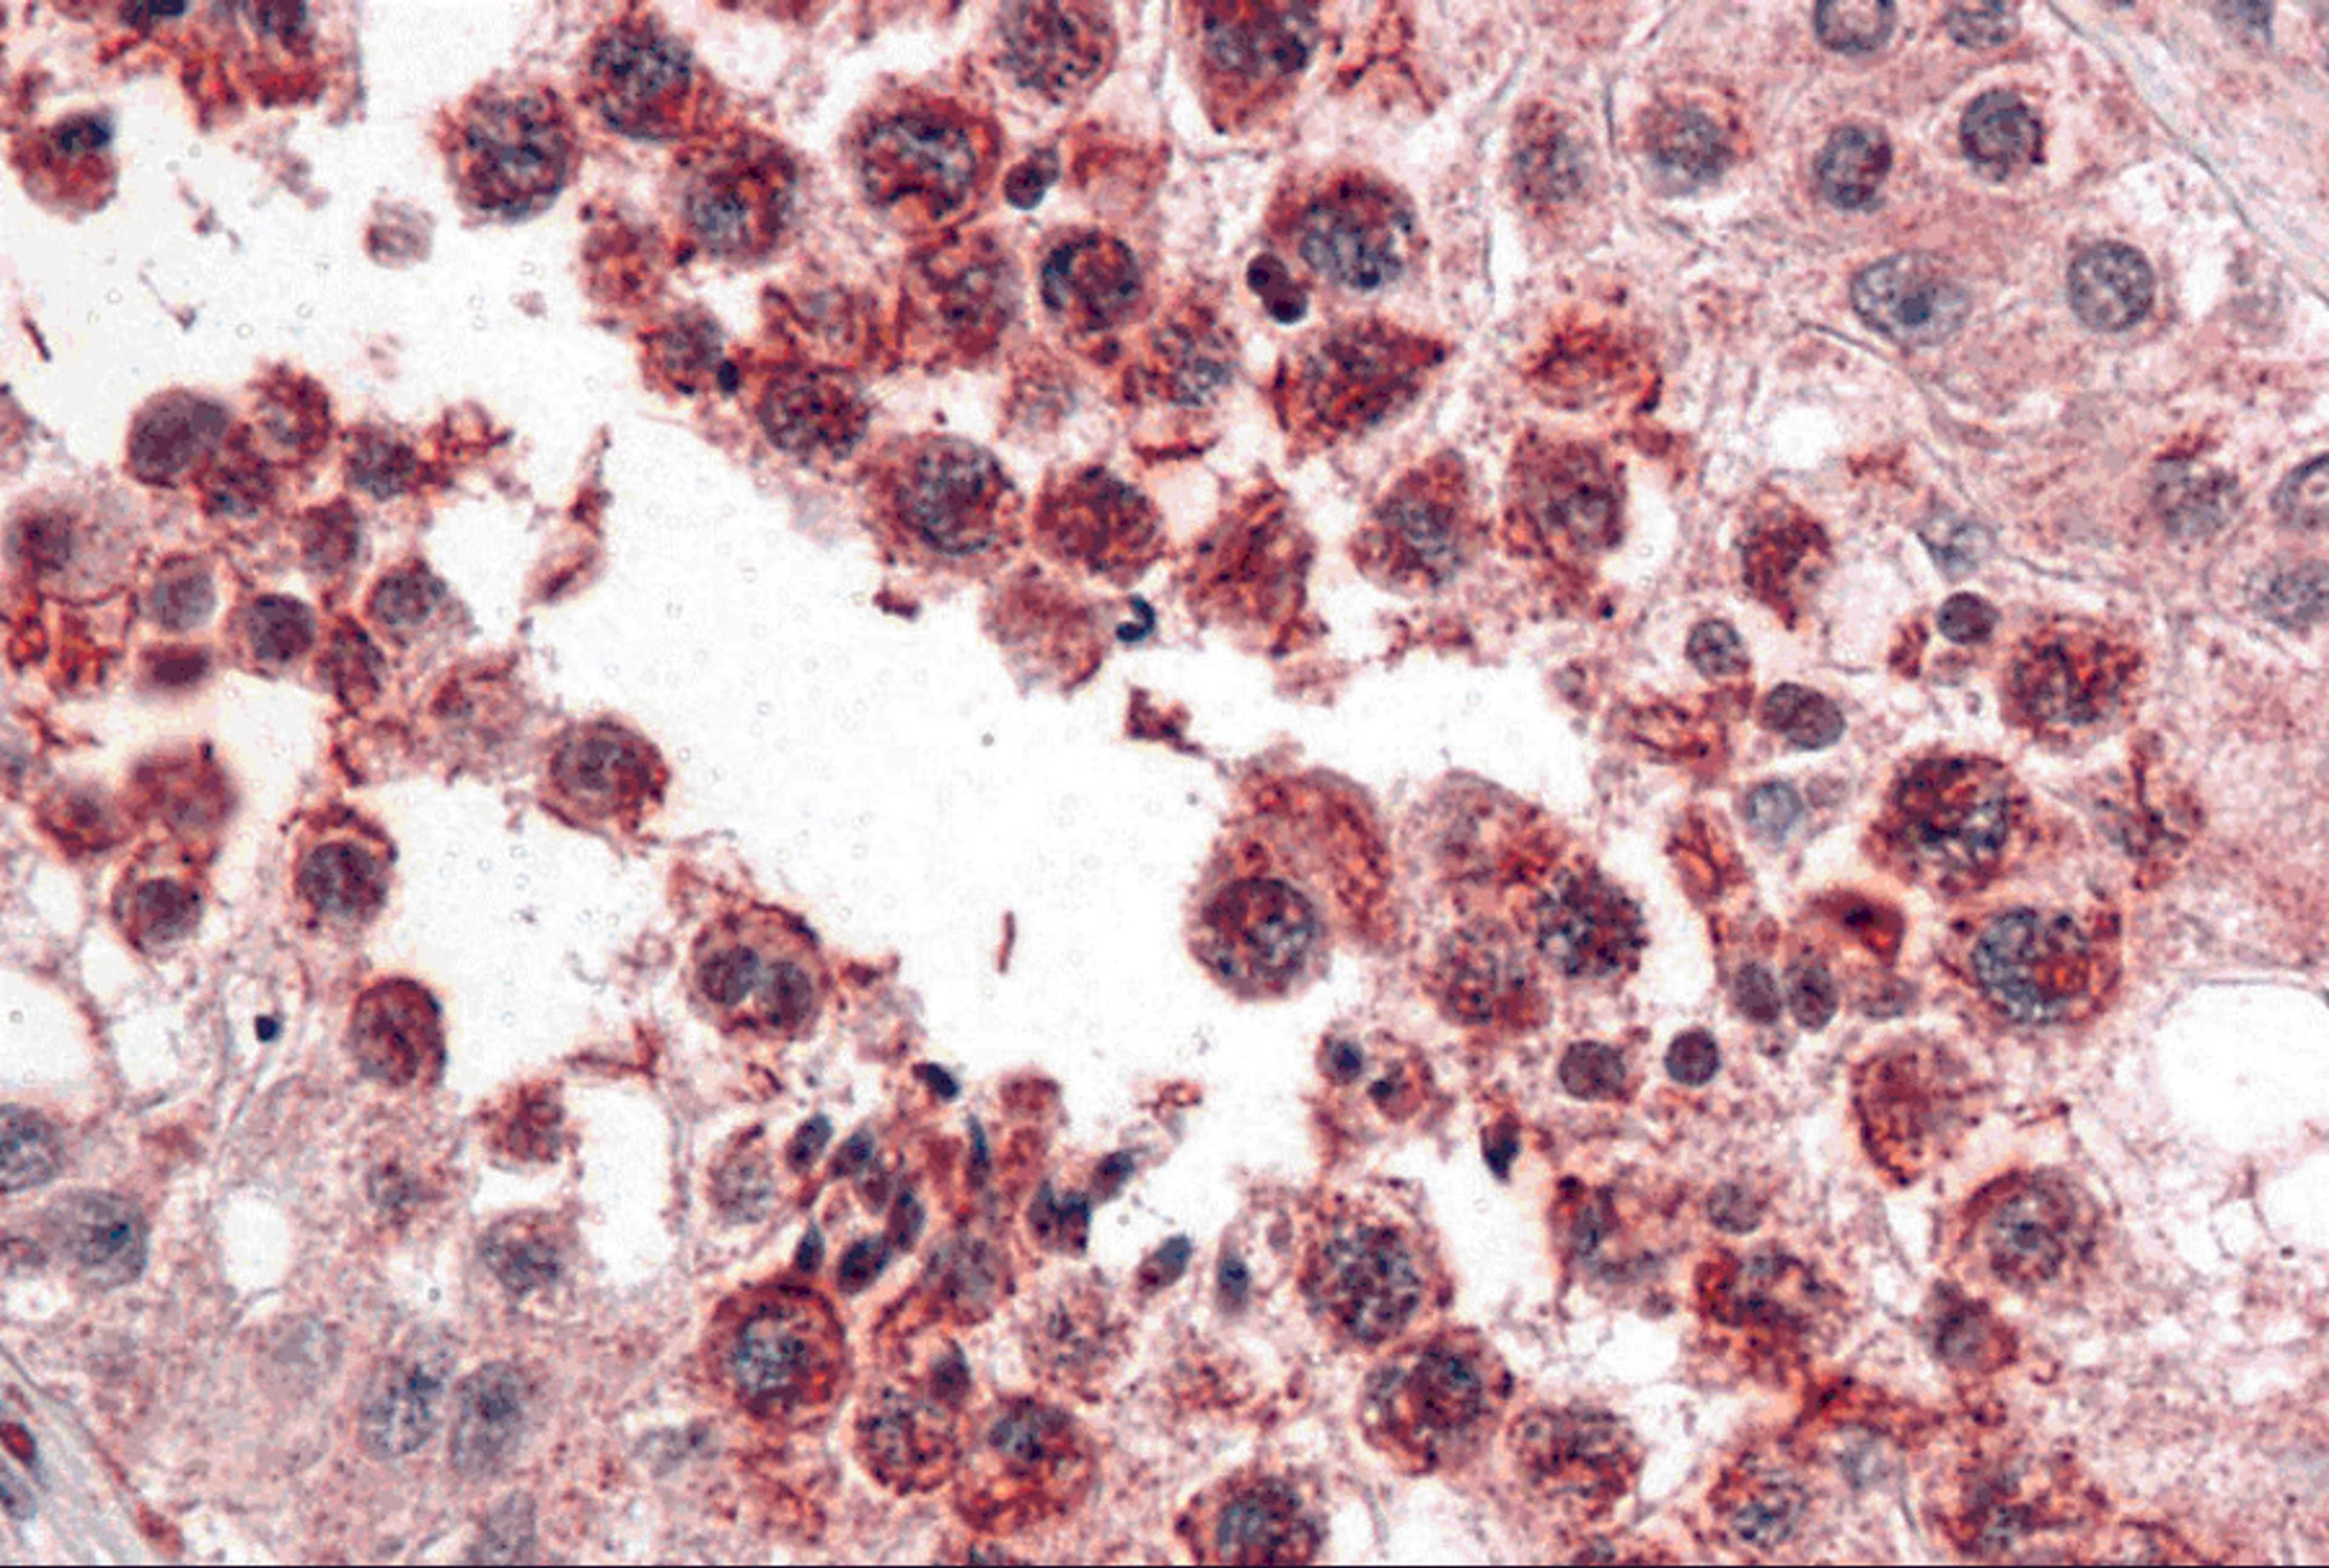
Immunohistochemistry of SLAIN2 in human testis with SLAIN2 antibody at 5 μg/mL.

Product & ReviewsAntibodies
SLAIN2 Antibody
Product Details
- Cat. No.
- 5471
- Type
- Primary Antibody
- Clonality
- Polyclonal
- Host
- Rabbit

The supplier does not provide quotations for this antibody through SelectScience. You can search for similar antibodies in our Antibody Directory.
Biological Information
- Clonality: Polyclonal
- Host: Rabbit
- Reactivity: Human
- Antigen: SLAIN2
- Isotype: IgG
- Source: SLAIN2 Antibody is affinity chromatography purified via peptide column.
- Gene: 57606
Handling
- Quantity: 0.02 mg, 0.1 mg
- Storage: SLAIN2 antibody can be stored at 4°C for three months and -20°C, stable for up to one year. As with all antibodies care should be taken to avoid repeated freeze thaw cycles. Antibodies should not be exposed to prolonged high temperatures.
- Buffer: SLAIN2 Antibody is supplied in PBS containing 0.02% sodium azide.
Applications
- ELISA (ELISA)
- Immunohistochemistry (Formalin-Fixed / Paraffin-Embedded Sections) (IHC (FP))